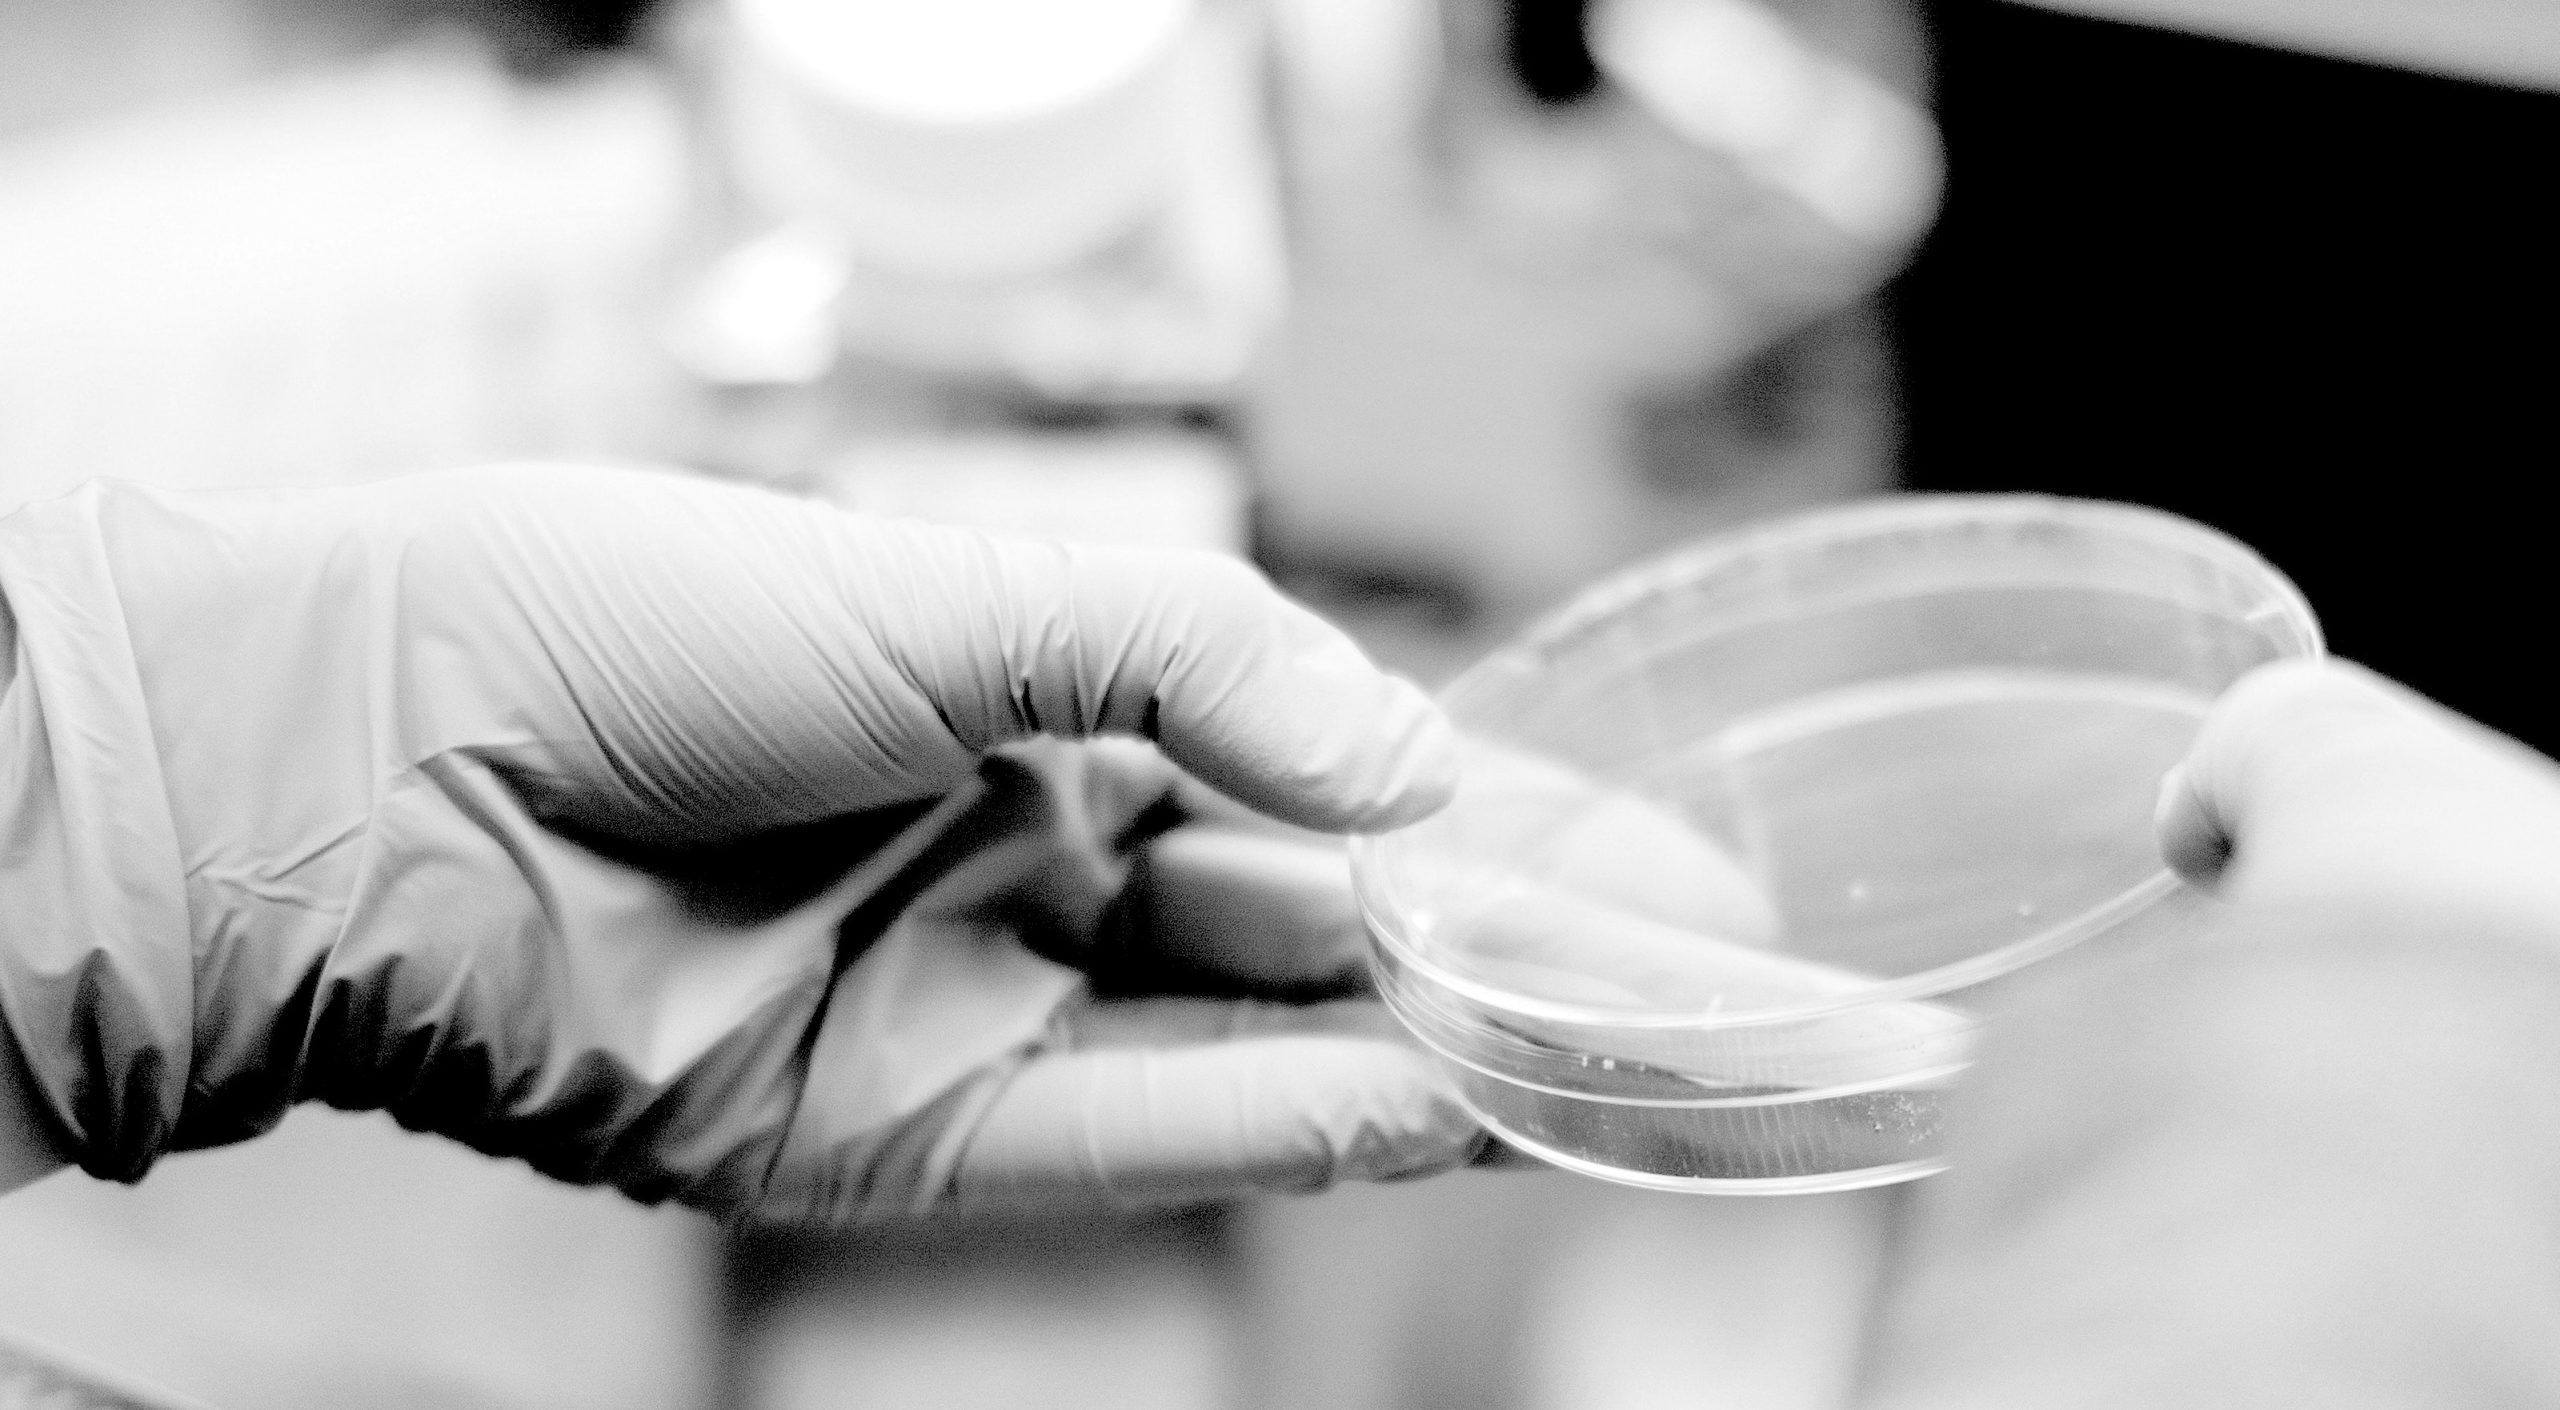

From Temple Law to Children’s Book Author, Catherine Nguyen (LAW ’10) Continues to Create Opportunity
December 11, 2023
Douglas Sasso (‘26) spotlights Cat Nguyen’s (LAW ’10) broad contributions to the legal profession and the community, and in the process finds some appetizing advice for law students.